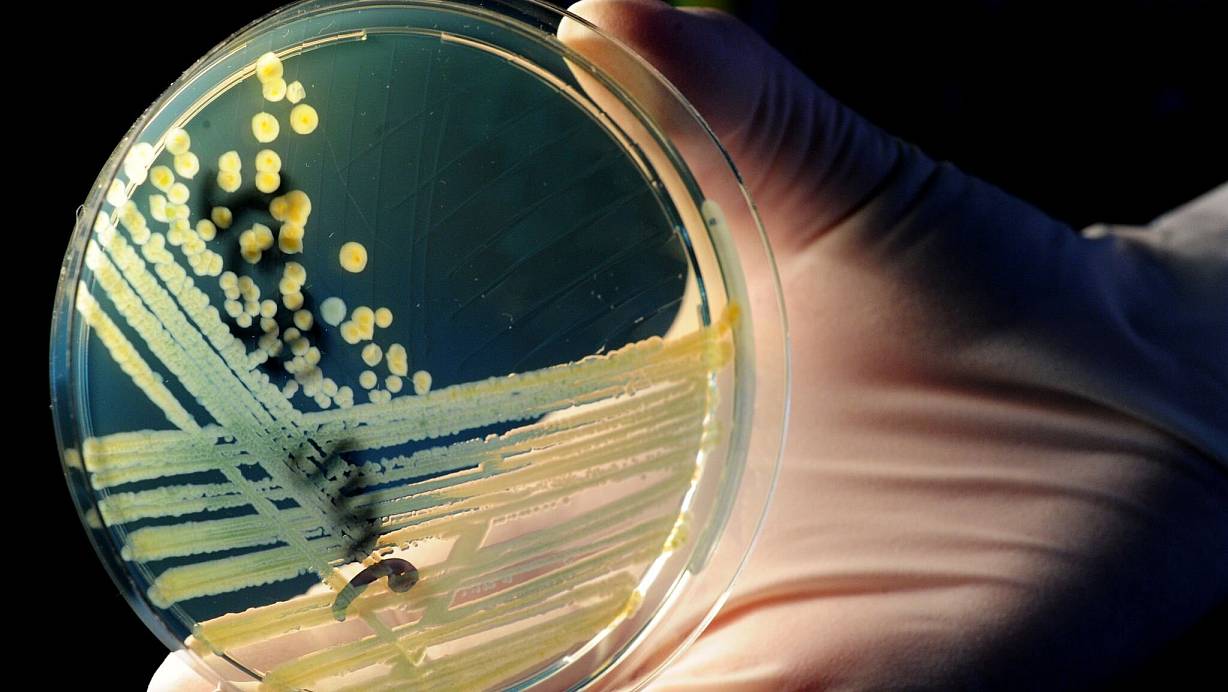
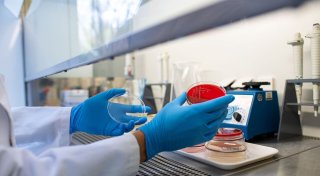

Nach Angaben des Robert Koch-Instituts gibt es keine Hinweise darauf, dass die jüngsten Ehec-Ausbrüche in Mecklenburg-Vorpommern und Belgien zusammenhängen. Bei den Erkrankten in belgischen Seniorenheimen sei ein anderer Ehec-Typ nachgewiesen worden, sagte eine RKI-Sprecherin der Deutschen Presse-Agentur.
Seit Mitte August sind nach aktuellen Angaben des Landesamtes für Gesundheit und Soziales (Lagus) 31 Menschen in Mecklenburg-Vorpommern an Ehec erkrankt (Stand Mittwoch). Die meisten von ihnen sind Kinder. 12 der Betroffenen entwickelten HUS, was zur Zerstörung der roten Blutkörperchen, Blutgerinnungsstörungen und Funktionsstörungen der Nieren führen kann. Von den Erkrankten werden nach Lagus aktuell 19 stationär behandelt. Die Ursache der Ehec-Infektionen ist den Angaben zufolge weiter unklar.
Aus Belgien sind nach Behördenangaben bislang 8 Todesfälle bekannt, Krankheitssymptome zeigten insgesamt 63 Personen (Stand 1. September). Den Angaben zufolge sind acht Heime betroffen, in vier weiteren finden noch Untersuchungen statt.
Kinder besonders gefährdet
Ehec-Ansteckungen gibt es regelmäßig. Im aktuellen Fall in Norddeutschland ist die Aufmerksamkeit dennoch hoch, unter anderem, weil so viele Kinder in recht kurzer Zeit von betroffen sind.
Ehec steht für enterohämorrhagische Escherichia coli und bezeichnet bestimmte krankmachende Stämme des Darm-Bakteriums, die vor allem bei Wiederkäuern wie Rindern vorkommen. Die Mikroben können zum Beispiel durch kontaminierte Lebensmittel auf den Menschen übertragen werden.
Sie produzieren sogenannte Shigatoxine: starke Zellgifte, die bei Menschen schwere Durchfallerkrankungen sowie das sogenannte hämolytisch-urämische Syndrom (HUS) verursachen können, eine Komplikation, die zu Nierenversagen führen kann. Kinder sind besonders gefährdet, weil ihr Immunsystem und ihre Organe noch nicht ausgereift sind.